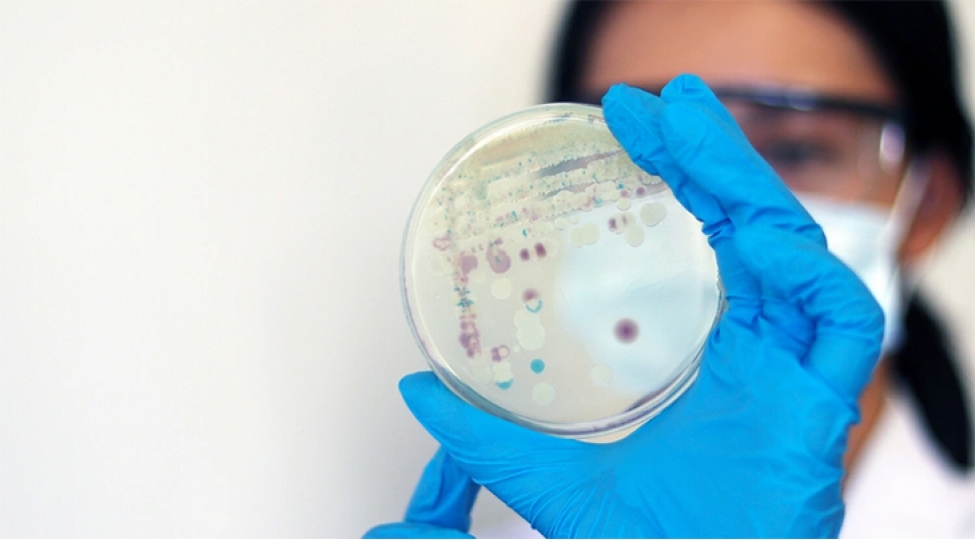

Yuta Universitetinin tədqiqatçıları, "Marquandomyces marquandii" adlı torpaq kifinin insanın yumşaq toxumalarını əvəz edə biləcək bənzərsiz hidrogel meydana gətirə biləcəyini müəyyənləşdiriblər.
“İki sahil” xəbər verir ki, tədqiqatın nəticələri "The Journal of the Minerals Metals & Materials Society" (JMMMS) jurnalında dərc olunub. Hidrogellər uzun müddətdir həkimlərin və mühəndislərin diqqətini çəkir - bu materiallar nəm saxlayır, dəri, qığırdaq və əzələlərə bənzəyən yumşaqlıq və elastikliyə malikdir.
Ancaq indiyə qədər sintetik analoqlar ya çox kövrək idi, ya da canlı hüceyrələrlə zəif qarşılıqlı əlaqədə idi.
Alimlərin fikrincə, laboratoriya tədqiqatlarında "M. marquandii" gözlənilməz xüsusiyyətlər nümayiş etdirib.
Maye qida mühitində böyüdükdə, suyun 83 %-ə qədərini saxlayan çoxqatlı lifli maddə yaradır. "Bu cür təbəqələrin fərqli məsamələri var – 40 % - dən 90 %-ə qədər, bu da müxtəlif növ toxumaların təqlidi üçün vacibdir. Gördüyümüz sözün əsl mənasında öz-özünə böyüyən hidrojeldir", - elmi əsərin müəlliflərindən biri, materialşünas Atul Aqraval izah edib.
Tədqiqatçılar ümid edirlər ki, gələcəkdə bu cür maddə hüceyrələrin böyüməsi, implantların yaradılması və ya hətta geyilə bilən bioloji qurğular üçün əsas kimi istifadə edilə bilər.
Yanıqların müalicəsi və ya protezlərin yaradılması üçün "göbələk dərisi" nin istifadəsi barədə danışmaq hələ tezdir, lakin alimlər tədqiqatları davam etdirmək niyyətindədirlər. Komanda göbələyin insanlar üçün nə qədər təhlükəsiz olduğunu öyrənməyi planlaşdırır - tərkibindəki xitinin nadir allergiyaya səbəb ola biləcəyi ehtimalı var.
 Gürcüstanın XİN rəhbəri: "Şəffaflıq haqqında qanun" gizli planların qarşısını aldı
Gürcüstanın XİN rəhbəri: "Şəffaflıq haqqında qanun" gizli planların qarşısını aldı